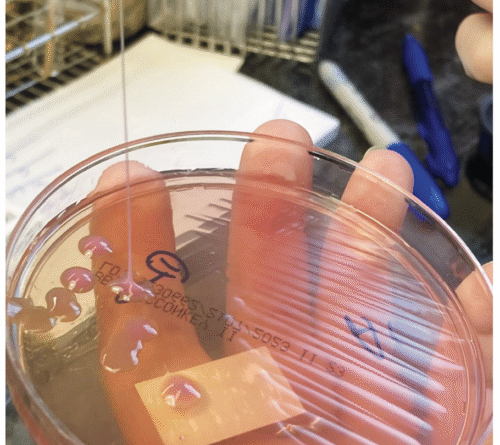
This may be the grossest eye pic ever—but the cause is what’s truly horrifying

Savage microorganism
Whatever was desolating his eye appeared to have actually originated from inside his own body, brought in his blood stream– perhaps the very same thing that might describe the liver mass, lung blemishes, and brain sores. There was one description that fit the condition completely: hypervirulent Klebsiella pneumoniae or hvKP.
Classical K. pneumoniae is a bacterium that stays in individuals’s intestinal tract systems and is one that’s familiar to physicians. It’s understood for prowling in healthcare settings and contaminating susceptible clients, frequently triggering pneumonia or urinary system infections. HvKP is really various. In contrast, it’s a beefed-up germs with a rage complex. It was initially determined in the 1980s in Taiwan– not for stalking weak clients in the health center however for ravaging healthy individuals in regular neighborhood settings.
An infection with hvKP– even in otherwise healthy individuals– is marked by metastatic infection. That is, the germs spreads out throughout the body, typically beginning with the liver, where it develops a pus-filled abscess. It then goes on a journey through the blood stream, getting into the lungs, brain, soft tissue, skin, and the eye (endogenous endophthalmitis). Putting all of it together, the guy had an entirely normal medical case of an hvKP infection.
Still, definitively recognizing hvKP is difficult. Mucous from the guy’s breathing system grew a types of Klebsiellahowever there’s not yet a strong diagnostic test to separate hvKP from the classical range. Because 2024, scientists have actually exercised a method of utilizing the existence of 5 various virulence genes discovered on plasmids (fairly little, circular pieces of DNA, different from chromosomal DNA, that can reproduce by themselves and be shared amongst germs.) The technique isn’t best– some classical K. pneumoniae can likewise bring the 5 genes.
A string test carried out on the unusual development of Klebsiella pneumoniae from the sputum culture reveals a favorable outcome, with the development of a thick string with a height of higher than 5 mm.
A string test carried out on the unusual development of Klebsiella pneumoniae from the sputum culture reveals a favorable outcome, with the development of a thick string with a height of higher than 5 mm.
Credit: NEJM 2026
Another much easier approach is the string test, in which clinicians essentially evaluate the goopy-ness of the germs– hvKP is understood for being sticky. For this test, a clinician grows the germs into a nest on a petri meal, then touches a shot loop to the nest and brings up. If the string of connected goo extends more than 5 mm off the petri meal, it’s thought about favorable for hvKP. This is (certainly) not an exact test.
Learn more
As an Amazon Associate I earn from qualifying purchases.







